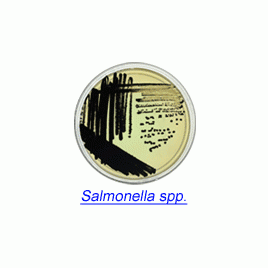

Product
제품
소개
Rainbow® Agar Salmonella (Dehydrated Media)
Chromogenic Media for Microbial Detection Less than 24 Hours
Rainbow Agar Salmonella utilizes an enhanced detection chemistry to determine H2S production among Salmonella spp.. Black colonies are formed by even weak H2S producing strains.
In addition, novel selective agents increase the recovery rate of Salmonella while inhibiting the growth of other enteric bacteria and inhibiting H2S production by Citrobacter and other H2S positive enteric species.


주문정보
80202 Rainbow® Agar Salmonella 47 g packet (approx. 50 plates)
관련자료